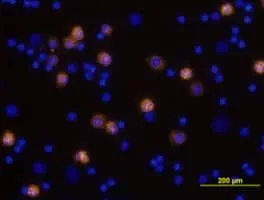

About Integrin Alpha M
Integrin alpha M is one protein subunit that forms heterodimeric integrin alpha-M beta-2 molecule, also known as macrophage-1 antigen or complement receptor 3. ITGAM is also known as CR3A, and cluster of differentiation molecule 11B.